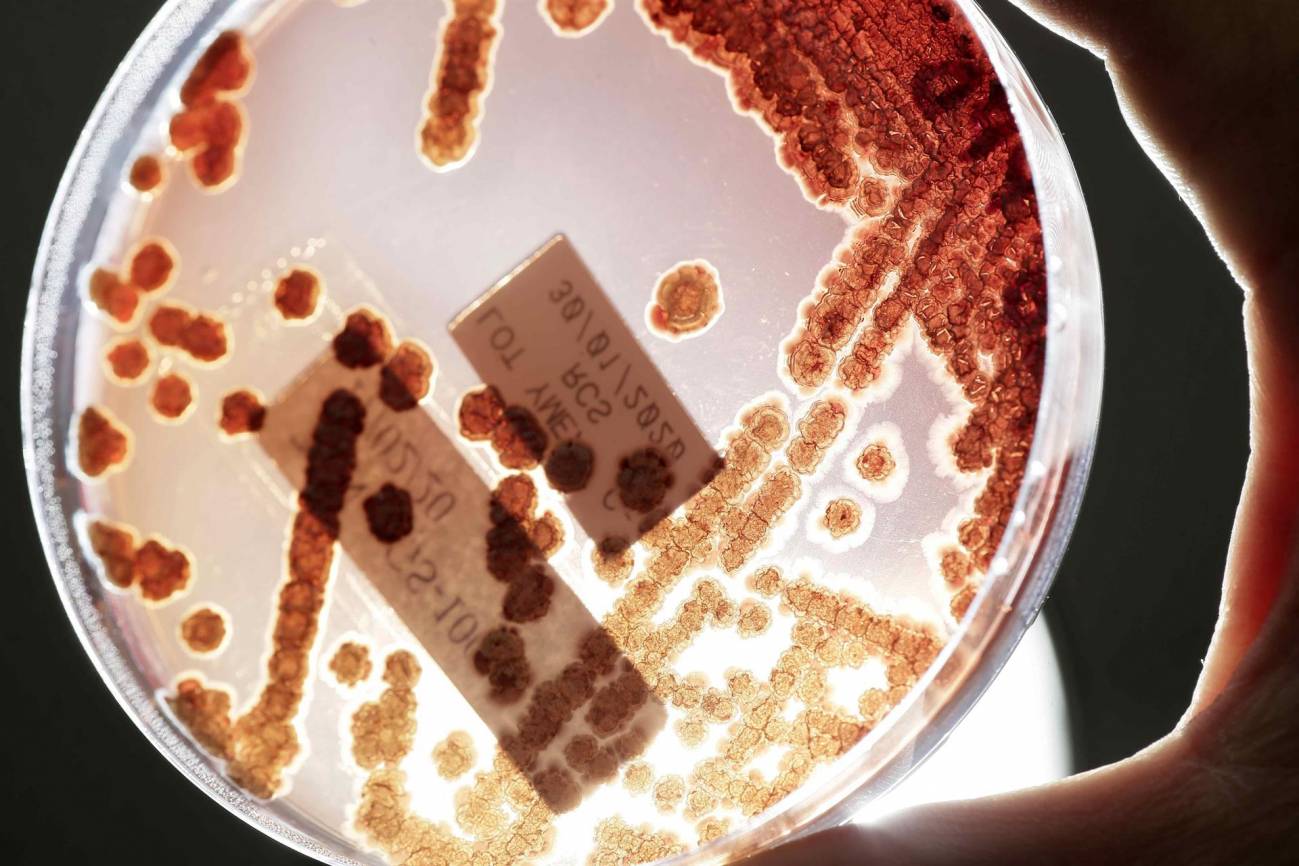

Agencia SINC
Mientras la covid-19 hace estragos, la pandemia de la resistencia a los antimicrobianos (AMR, por sus siglas en inglés) continúa en la sombra. Sus consecuencias para los pacientes y sus familias son en gran medida invisibles, pero se reflejan en infecciones bacterianas prolongadas que alargan las estancias en los hospitales y causan muertes innecesarias.
Ahora, un nuevo estudio, realizado con datos de 204 países y territorios, revela que la AMR se ha convertido en una de las principales causas de muerte en todo el mundo, por encima de enfermedades como el sida y la malaria. El análisis, publicado en The Lancet, estima que esta resistencia causó 1,27 millones de fallecimientos en 2019, y que las infecciones resistentes a los antimicrobianos estuvieron vinculadas a 4,95 millones de muertes.
Chris Murray, del Instituto de Métrica y Evaluación de la Salud de la Universidad de Washington (EE UU) y coautor del trabajo, señala que “estos nuevos datos revelan la verdadera magnitud de la resistencia a los antimicrobianos en todo el mundo, y son una clara señal de que debemos actuar ya para combatir la amenaza”.
“Las estimaciones anteriores preveían 10 millones de muertes anuales por resistencia a los antimicrobianos para 2050, pero ahora sabemos con certeza que ya estamos mucho más cerca de esa cifra de lo que pensábamos”, añade el experto.
Mayor estudio realizado hasta el momento
La nueva investigación global sobre la resistencia antimicrobiana, el mayor estudio de este tipo llevado acabo hasta ahora, estima las muertes relacionadas con 23 patógenos y 88 combinaciones patógeno-fármaco en 204 países y territorios en el año 2019.
Para ello, los autores utilizaron 471 millones de historiales individuales obtenidos a partir de diferentes fuentes de datos. Además, dividieron los fallecimientos en dos tipos: muertes causadas directamente por AMR, es decir, aquellas que no se habrían producido si las infecciones fueran susceptibles a los medicamentos; y las vinculadas a AMR, que son las que produjeron por una infección farmacorresistente, pero que no se tiene la certeza de si fue la causa directa de la muerte.
Según los resultados del análisis, en 2019 la AMR provocó de forma directa 1,27 millones de muertes en todo el mundo, y se asoció con aproximadamente 4,95 millones de fallecimientos. Se estima que el sida y la malaria causaron 860.000 y 640.000 muertes, respectivamente, ese mismo año.
Las infecciones farmacorresistentes que más muertes causaron fueron las respiratorias –como la neumonía–, con más de 400.000 directas y vinculada a más de 1,5 millones; las del torrente sanguíneo, que provocaron alrededor de 370.000 muertes y se asociaron a casi 1,5 millones de fallecimientos; y las intraabdominales –como la apendicitis–, que produjeron directamente unas 210.000 defunciones y se relacionaron con otras 800.000.
Riesgo alto en niños y países pobres
Aunque la AMR supone una amenaza para personas de todas las edades, la población infantil corre un riesgo especialmente elevado: una de cada cinco muertes atribuibles a la AMR se produce en niños o niñas menores de cinco años.
Se estima que las muertes causadas directamente por la AMR son más altas en el África subsahariana y en el sur de Asia, con 24 y 22 fallecimientos por cada 100.000 habitantes, respectivamente. Además, se asoció a 99 muertes por cada 100.000 habitantes en el África subsahariana y a 77 por cada 100.000 habitantes en el sur de Asia.
En los países de ingresos altos, la AMR provocó directamente 13 muertes por cada 100.000 habitantes y se asoció a 56 muertes por cada 100.000 habitantes.
De los 23 patógenos estudiados, la farmacorresistencia de seis de ellos (E. coli, S. aureus, K. pneumoniae, S. pneumoniae, A. baumannii y P. aeruginosa) provocó directamente 929.000 muertes y se asoció a 3,57 millones.
Sin embargo, el impacto de estos patógenos varía según el lugar. Las defunciones en África subsahariana fueron causadas con mayor frecuencia por S. pneumonia (16 %) o K. pneumonia (20 %), mientras que alrededor de la mitad de las muertes atribuibles a la ARM en los países de ingresos altos fueron causadas por S. aureus (26 %) o E. coli (23 %).
Necesidad de actuar frente a esta amenaza
“Dado que la resistencia varía tan sustancialmente según el país y la región, es esencial mejorar la recopilación de datos en todo el mundo para ayudarnos a hacer un mejor seguimiento de los niveles de resistencia y dotar a los médicos y a los responsables políticos de la información que necesitan para abordar los retos más acuciantes que plantea la resistencia a los antimicrobianos”, afirma la coautora del estudio, Christiane Dolecek, del Centro de Medicina Tropical y Salud Global de la Universidad de Oxford y la Unidad de Investigación de Medicina Tropical de Mahidol Oxford.
“Incluso la cifra más baja de 911.000 muertes estimada por Murray y sus colegas es superior a la del VIH, que atrae cerca de 50.000 millones de dólares al año. Sin embargo, el gasto mundial para hacer frente a la AMR es probablemente mucho más bajo que eso”, señala en un comentario vinculado al estudio Ramanan Laxminarayan, del Center for Disease Dynamics, Economics & Policy (EE UU).
La inversión rápida en nuevos tratamientos, la mejora de las medidas de control de las infecciones y la optimización del uso de los antibióticos son algunas de las medidas que pueden ayudar a los países a proteger sus sistemas sanitarios contra la amenaza de la AMR.
“Los líderes sanitarios y políticos a escala local, nacional e internacional deben tomarse en serio la importancia de abordar la AMR y el reto que supone el escaso acceso a antibióticos asequibles y eficaces”, concluye el experto.
Referencia:
Murray et al. “Global burden of bacterial antimicrobial resistance in 2019: a systematic analysis”. The Lancet.